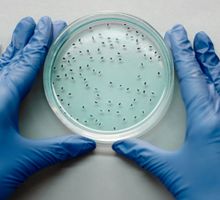
MitoCatch, un GPS celular que dirige mitocondrias sanas hacia células dañadas

Cali, abril 17 de 2026. Actualizado: viernes, abril 17, 2026 21:05
Revela estudio de metabolismo
Semaglutida mejora la salud del hígado sin depender de la pérdida de peso

Un estudio publicado en la revista Cell Metabolism y realizado entre la Universidad de Toronto y el Centro de Investigación en Medicina Molecular (ambos en Canadá) concluye que la semaglutida, un fármaco basado en GLP‑1, ejerce efectos directos sobre el hígado que no dependen de la pérdida de peso.
La investigación analiza cómo el medicamento reduce la inflamación y la fibrosis y favorece la regeneración del tejido hepático en modelos experimentales.
Los autores identifican que el receptor de GLP‑1 —la diana terapéutica de la semaglutida— está presente en un tipo específico de células endoteliales del hígado que coordinan su funcionamiento.
Al activarse, ese receptor desencadena una red de señales que modula la respuesta inflamatoria y la cicatrización, lo que explica la mejora hepática observada en algunos pacientes incluso antes de perder grasa corporal de forma notable.
La enfermedad hepática metabólica afecta aproximadamente al 30 % de la población mundial y hasta ahora se pensaba que las mejoras con estos fármacos eran consecuencia indirecta de la pérdida de peso.
Como explica María Jesús González Rellán, autora principal e investigadora del CiMUS, “identificar estos mecanismos directos ayuda a entender mejor su eficacia y abre la puerta a desarrollar terapias más específicas y a determinar qué pacientes pueden beneficiarse más de estos tratamientos”.
Mecanismo directo en células endoteliales sinusoidales del hígado
El hallazgo cambia la comprensión sobre la acción de los medicamentos GLP‑1: más allá de su efecto sobre el apetito y el metabolismo, la semaglutida podría tener un papel protector directo sobre el hígado.
Los investigadores señalan que estos resultados permitirán diseñar estrategias terapéuticas más dirigidas, aunque subrayan que hacen falta más estudios clínicos para confirmar la relevancia en pacientes y definir qué subgrupos se beneficiarán más.
El estudio, referenciado como Rellán M.J. et al., The weight-loss-independent hepatoprotective benefits of semaglutide are orchestrated by intrahepatic sinusoidal endothelial GLP‑1 receptors, aparece en Cell Metabolism (2026).
Los autores y la nota de la Agencia SINC recuerdan además que el acceso a estos fármacos no es universal, por lo que cualquier avance científico debe considerarse junto a cuestiones de equidad y regulación sanitaria.